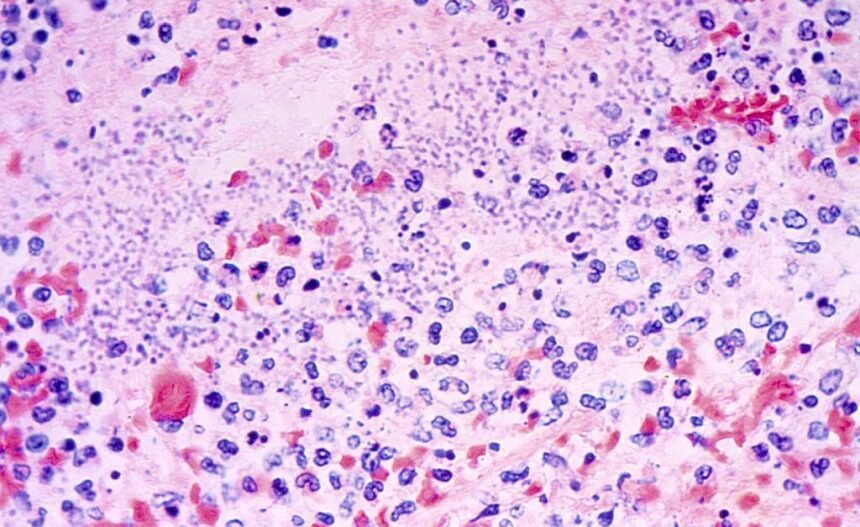

A person in Arizona has died from pneumonic plague, local health officials said on Friday.
Pneumonic plague, which occurs when the bacterium Yersinia pestis gets into a person’s lungs, is both “the least common and most dangerous type of plague,” according to the Cleveland Clinic.
All three major types of the plague are rare in the modern day. One type, bubonic plague, was the main cause of the fourteenth century’s Black Death pandemic, which left a trail of death and devastation across Europe. Now, roughly 1,000 to 2,000 people across the globe are diagnosed with plague annually, per the Cleveland Clinic. Only around seven cases are reported in the U.S. each year.
It is unclear when the person in Arizona died, but the Coconino County health department said in a press release that it received test results Friday that confirmed the patient had pneumonic plague.
Here’s what to know about pneumonic plague.
Where do most cases of plague happen, and who is most at risk of infection?
In recent years, plague has most commonly been found in Africa, according to the World Health Organization. It remains endemic in some countries, primarily the Democratic Republic of Congo, Madagascar, and Peru.
“In the U.S., you’re more likely to get plague in rural areas of western states,” according to the Cleveland Clinic. “You’re at higher risk if you work with animals in an area where plague is found.”
How does pneumonic plague spread?
Pneumonic plague is the only type of plague that can be transmitted from person to person, according to the U.S. Centers for Disease Control and Prevention (CDC). Person-to-person transmission can happen through coughing and sneezing, according to the Cleveland Clinic. But a person could also get the disease after close contact with an animal infected with it, or from bacteria moving from another part of the body to the lungs.
In general, plague typically spreads through bites from fleas that had bitten an animal infected with the bacteria.
According to the CDC, U.S. officials have not documented person-to-person spread of plague in the country since 1924, but “there continue to be rare cases of pneumonic plague among people exposed to sick cats.” Cats, the CDC said on its website, “are particularly susceptible to plague and can be infected by eating infected rodents.”
How can I protect myself against it?
The Cleveland Clinic advises people to minimize their risk of plague by avoiding flea bites and exercising caution around animals that could be infected with the bacteria. The clinic recommends taking actions including wearing bug spray with DEET, wearing gloves when dealing with animals that could be infected, and not allowing pets to wander around outside if located in an area that is known to have plague.
A plague vaccine is not currently available in the U.S., according to the CDC. While scientists are working on developing such vaccines in the U.S., the CDC said, they “are not expected to be commercially available in the immediate future.”
Globally, the World Health Organization recommends vaccination against plague only for high-risk groups, including health care workers and people working in laboratories who are in constant danger of exposure.